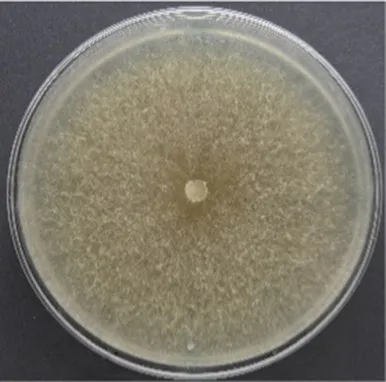
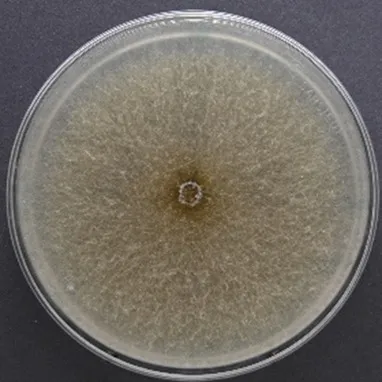
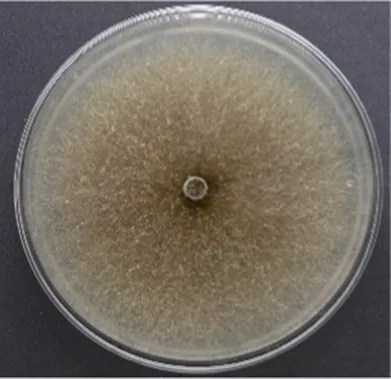
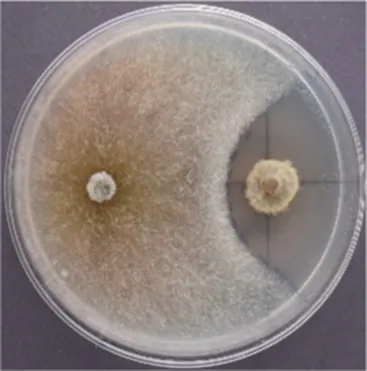
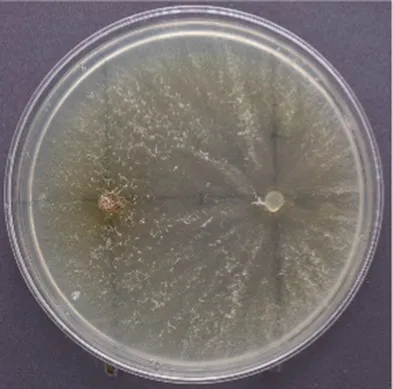
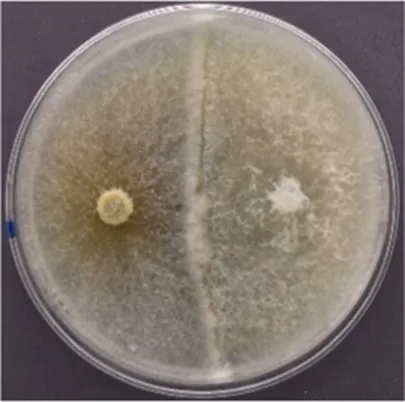
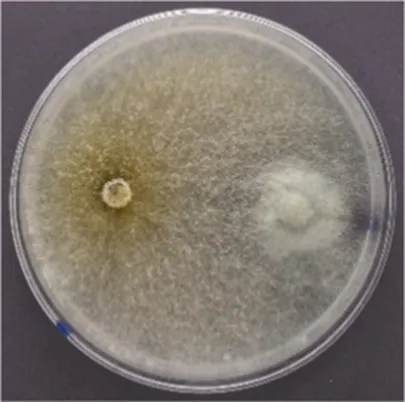

Abstract
In an effort to find a potential antagonist for Cryptostroma corticale, the causal agent of the sooty bark disease, different fungi previously isolated from Acer pseudoplatanus were tested in dual culture antagonism assays with C. corticale. In total 102 fungal strains, mainly Ascomycota, were tested. Each potentially antagonistic strain was paired with three different strains of C. corticale. Four different tests were conducted to get a better understanding of the interactions between C. corticale and the potential antagonists. Test 1 was a dual culture set up at room temperature with all 102 strains to get an overview of the interactions with C. corticale, as well as placing the potential antagonist on a Petri dish 1 week prior to C. corticale for a selection of fungi. For Test 2, only fungi which showed inhibition at distance in Test 1 were chosen and tested on different media at 25°C, the optimal growing temperature of the pathogen. In Test 3, fungi showing signs of antagonism in Test 1 were tested against C. corticale in a 6:1 ratio of potential antagonist plugs to the C. corticale plug. For Test 4, the viability of C. corticale hyphae was tested after they stopped growing in dual culture with a potential antagonist. These in vitro trials show that C. corticale displays a very competitive behavior, overgrowing most of the tested fungi. However, nine of the tested fungal strains, showed an antagonism at distance for at least one of the C. corticale strains. Over all tests, Hypholoma fasciculare, Jackrogersella cohaerens, Paracamarosporium cf. fagi, Pezicula sporulosa, and Preussia cf. aemulans showed the highest potential in regard of functionality as a biological control agent.
1 Introduction
Cryptostroma corticale (Ellis & Everh.) P. H. Greg. & H. Waller is the causal agent of the sooty bark disease (SBD) in Acer trees (Ellis and Everhart, 1889; Gregory and Waller, 1951). It was originally described in 1889 by Ellis and Everhart (1889) as Coniosporium corticale from Canada, where it is considered native. It was first detected in Europe in 1945 in Wanstead Park in London, Great Britain by Gregory and Waller (1951) and was also detected around the same time in Paris, France by Moreau and Moreau (1951). The first detection of the disease in Germany dates back to 1964, when it was found on stored wood in a basement in Berlin (Plate and Schneider, 1965). Due to exceptionally warm and dry summers in central Europe in the recent past (Bastos et al., 2020; Schuldt et al., 2020; Hänsel et al., 2022), the SBD has become even more prominent. The disease is associated with wilt symptoms, yellowing of the leaves and wood discoloration (Gregory and Waller, 1951; Dickenson, 1980), which devalues timber of Acer trees. The spores produced by the pathogen can cause extrinsic allergic alveolitis or hypersensitivity pneumonitis in humans (Towey et al., 1932; Braun et al., 2021), though there have been no recent reports from Europe. The SBD is present in several European countries such as the Czech Republic, France, Germany, Italy, Switzerland, and the United Kingdom (Gregory and Waller, 1951; Oliveira Longa et al., 2016; Kelnarová et al., 2017; Muller et al., 2023). Some disease outbreaks in Germany have led to the felling of entire severely damaged stands.
Cryptostroma corticale is considered to be an opportunistic pathogen and has been described as a saprotroph (Young, 1978). It was assumed to have an endophytic life stage (Sieber, 2007), becoming pathogenic only under favorable conditions for the pathogen (Enderle et al., 2020), for example heat and drought (Dickenson, 1980; Dickenson and Wheeler, 1981; Eastburn et al., 2011; Enderle et al., 2020). The response of plants to drought and temperature stress may influence other stress responses of plants, including those toward pathogens (Eastburn et al., 2011), and in turn be beneficial for emerging pathogens (Desprez-Loustau et al., 2007), such as C. corticale. The optimal growing temperature for C. corticale is 25°C (Dickenson, 1980), making rising summer temperatures increasingly suitable for the pathogen. The endophytic stage of C. corticale has recently been demonstrated by Schlößer et al. (2023). The systematic placement of C. corticale is still being discussed. Molecular analysis showed that C. corticale belongs to the Graphostromataceae M.E. Barr, J.D. Rogers & Y.M. Ju, Xylariales Tul. & C. Tul. (Koukol et al., 2014). According to the study of Koukol et al. (2014), its closest relatives are Biscogniauxia bartholomaei (Peck) Lar. N. Vassiljeva and Graphostroma platystomum (Schwein.) Piroz.
There are currently no means available to control C. corticale in the living host tree. Fungal antagonists capable of colonizing the same habitat as C. corticale present a promising option for biological control due to their endophytic life stage. The use of beneficial living organisms for pest control is broadly defined as biological control (Kenis et al., 2019). Biological control agents (BCA) can promote positive reactions in the plant and reduce negative effects caused by plant pathogens (Shoresh et al., 2010). Species of the genus Trichoderma have been recognized for their potential as BCA against plant pathogens since the early 1930s (Howell, 2003). BCA ideally should be organisms that do not cause harm to the target plant, such as fungi in their endophytic stage. Endophytes can modify the severity and expression of host plant diseases through their interaction with pathogens (Busby et al., 2016). Through these interactions endophytes are able to antagonize pathogens via different mechanisms like competition, hyperparasitism or antibiosis (Busby et al., 2016), and can thus function as biological control. BCA are primarily researched in agriculture (Busby et al., 2016) due to this field’s economic importance as well as the one-year life-cycle of crops as opposed to the life span of a forest tree (Pratt et al., 1999). A commonly used biocontrol method in agriculture is treating seeds with an antagonist of a problematic pathogen to prevent the initial establishment of the pathogen in the target plant, as described for treatment of tomato seeds with Trichoderma harzianum Rifai and T. koningii Oudem. strains for protection against Pythium sp. (Harman and Taylor, 1988; Taylor and Harman, 1990; Harman, 1991). There are only a few examples from forestry, such as Phlebiopsis gigantea (Fr.) Jülich against Heterobasidion annosum s.l. (Fr.) Bref., which causes root rot (Rishbeth, 1963; Greig, 1976), and Cryphonectria hypovirus 1 (CHV1), which is effective against Cryphonectria parasitica (Murr.) Barr causing cankers on Castanea spp. (Heiniger and Rigling, 1994; Rigling and Prospero, 2018).
A number of different techniques and methods have been used to study fungal antagonisms, like observing interactions between hyphae and clustering the interactions as types (Yuen et al., 1999). In order to identify such interactions, in vitro experiments have to be conducted to investigate the specific interaction between two different fungi. Different interactions between fungi in vitro have previously been described by Boddy (2000), namely deadlock and replacement. Deadlock describes a hyphal interaction where both fungi stop their growth, whereas replacement happens when one fungal culture overgrows, i.e., replaces, the other (Boddy, 2000).
The aim of this study was to gain insights into the in vitro interaction between the non-native invasive species C. corticale and other fungi occurring naturally in sycamore maple (Acer pseudoplatanus L.) in Germany. The objective was to identify a fungus which might be a candidate to be used as a BCA against C. corticale. For this, four dual culture tests between C. corticale and different potentially antagonistic fungal strains isolated from sycamore were conducted: Test 1 to get an overview of the fungal interactions, Test 2 to see if different types of media and the optimal growing temperature of the pathogen have an influence on the interactions, Test 3 to investigate whether C. corticale can compete in a growth challenge against six agar plugs colonized by the potentially antagonistic fungus, and Test 4 in order to test viability of hyphal tips of C. corticale after they stopped growing in an interaction.
2 Materials and methods
In order to determine the interaction between C. corticale strains and the fungi isolated from sycamore maple (hereafter “potential antagonists”) by Schlößer et al. (2023), four tests were carried out (Figure 1). Three different strains of C. corticale (CC1: NW-FVA 5889, CC2: NW-FVA 7011 and CC3: NW-FVA 7148; Table 1) with different geographical origins and slight differences in the habitus of their pure cultures were chosen for the experiment and used in all four tests. The three C. corticale strains behaved very similar in pure culture in terms of growth rate. The 76 potential antagonistic taxa (102 strains) used in this study (Table 2) were obtained from wood core borings and mainly belong to the Ascomycota (88%) and to a lesser extent to the Basidiomycota (11%), one Mucoromycota and one tested fungus could not be taxonomically placed (Fungus sp.). Sampling, isolation, and storage of fungal cultures is described in Schlößer et al. (2023). The types of media used in this study were malt yeast peptone agar (MYP), modified according to Langer (1994), and potato dextrose agar (PDA), following the instructions of the manufacturer (Fluka). All 90 mm Petri dishes, were filled with 20 mL of the respective nutrient media.
Figure 1

Flowchart illustrating the selection of fungal strains for experiments.
Table 1
| C. corticale strain number | Referred to as | NCBI accession-No. | Origin of isolation | Isolated from (material) | Culture habitus after 10 days on MYP at room temperature |
|---|---|---|---|---|---|
| NW-FVA 5889 | CC1 | OP010050 | Bomstedt, Saxony-Anhalt | Spores from young stem with blisters |
|
| NW-FVA 7011 | CC2 | PP448053 | Hardberg, Hesse | Living woody tissue |
|
| NW-FVA 7148 | CC3 | PP448054 | Dransfeld, Lower-Saxony | Spores from laying wood (bark) |
|
List of Cryptostroma corticale-strains, isolated in Germany, used in the dual culture tests.
Table 2
| Sequenced as | Accession no. | NW-FVA no. | Division1 | Order2 | Interaction type based on Test 1 | ||
|---|---|---|---|---|---|---|---|
| CC1 | CC2 | CC3 | |||||
| Agaricales sp. | ON710962 | 7192 | B | Agaricales | V | V | V |
| Angustimassarina sp. | ON710906 | 6253 | A | Pleosporales | V | V | V |
| Angustimassarina sp. | PP448033 | 6254 | A | Pleosporales | V | V | V |
| Angustimassarina sp. | PP448034 | 6427 | A | Pleosporales | V | V | V |
| Angustimassarina sp. | PP448035 | 6587 | A | Pleosporales | V | V | V |
| Apiognomonia sp. | ON710918 | 6272 | A | Diaporthales | V | V | V |
| Apiospora kogelbergensis | PP448038 | 7713 | A | Amphisphaeriales | IV | IV | V |
| Apiospora cf. marii | ON710953 | 7004 | A | Amphisphaeriales | V | V | IV |
| Apiospora cf. marii | PP448037 | 7006 | A | Amphisphaeriales | V | V | V |
| Apiospora cf. marii | PP448036 | 7013 | A | Amphisphaeriales | IV | IV | IV |
| Apiospora rasikravindrae | ON710949 | 6999 | A | Amphisphaeriales | V | V | V |
| Aureobasidium sp. | ON710936 | 6586 | A | Dothideales | V | V | V |
| Beauveria pseudobassiana | ON710933 | 6581 | A | Hypocreales | I | I | I |
| Biscogniauxia nummularia | ON710888 | 6227 | A | Xylariales | IV | IV | IV |
| Boeremia exigua | ON710928 | 6430 | A | Pleosporales | V | V | V |
| Cadophora prunicola | ON710939 | 6596 | A | Helotiales | V | V | V |
| Cadophora prunicola | PP448039 | 6996 | A | Helotiales | II | I | I |
| Calosporella innesii | ON786729 | 6573 | A | Diaporthales | II | II | II |
| Capronia sp. | ON710913 | 6262 | A | Chaetothyriales | V | V | V |
| Cephalotrichum sp. | PP448032 | 6247 | A | Hypocreales | V | I | II |
| Cladosporium sp. 2 | ON710963 | 7195 | A | Capnodiales | V | V | V |
| Cladosporium sp. 3 | ON710910 | 6259 | A | Capnodiales | V | V | V |
| Cladosporium sp. 5 | ON710944 | 6991 | A | Capnodiales | V | V | V |
| Clonostachys rosea | ON710898 | 6243 | A | Hypocreales | II | II | II |
| coelomycete | DNA extraction failed | 7709 | A | V | V | II | |
| Coprinellus micaceus | ON710893 | 6233 | B | Agaricales | V | V | V |
| Coprinellus sp. | ON710950 | 7000 | B | Agaricales | III | III | III |
| Cytospora cf. friesii | ON710902 | 6249 | A | Diaporthales | V | V | V |
| Cytospora cf. populina | ON710895 | 6237 | A | Diaporthales | V | V | V |
| Cytospora cf. populina | PP448055 | 6240 | A | Diaporthales | V | V | V |
| Cytospora cf. populina | PP448056 | 6242 | A | Diaporthales | V | V | V |
| Cytospora cf. populina | PP448042 | 6421 | A | Diaporthales | V | V | V |
| Cytospora cf. rodophila | PP448040 | 6235 | A | Diaporthales | V | V | V |
| Cytospora cf. rodophila | PP448041 | 6268 | A | Diaporthales | V | V | V |
| Cytospora cf. rodophila | PP448057 | 6269 | A | Diaporthales | V | V | V |
| Diaporthe cf. eres | ON710970 | 7714 | A | Diaporthales | IV | V | V |
| Diaporthe cf. rudis | ON710952 | 7002 | A | Diaporthales | V | V | V |
| Diaporthe cf. rudis | PP448043 | 7012 | A | Diaporthales | V | V | V |
| Diaporthe pustulata | ON710889 | 6228 | A | Diaporthales | II | II | II |
| Didymella macrostoma | ON710899 | 6244 | A | Pleosporales | V | V | V |
| Didymella macrostoma | PP448044 | 6593 | A | Pleosporales | V | V | V |
| Didymellaceae sp. | ON710948 | 6998 | A | Pleosporales | IV | IV | IV |
| Dothideomycetes sp. | ON710927 | 6429 | A | i.s. | V | V | V |
| Dothiorella spp. | ON710891 | 6230 | A | Botryosphariales | V | V | V |
| Eutypa maura | PP448058 | 7018 | A | Xylariales | IV | IV | IV |
| Eutypa maura | ON710900 | 6245 | A | Xylariales | IV | IV | IV |
| Eutypa petrakii var. hederae | ON710915 | 6267 | A | Xylariales | V | V | IV |
| Eutypella quaternata | ON710896 | 6238 | A | Xylariales | II | II | II |
| Exophiala cf. pisciphila | ON710924 | 6423 | A | Chaetothyriales | V | V | V |
| Hymenochaeta sp. | ON710956 | 7019 | B | Hymenochaetales | V | V | V |
| Hypholoma fasciculare | ON710897 | 6241 | B | Agaricales | II | I | II |
| Hypoxylon fragiforme | ON710966 | 7707 | A | Xylariales | IV | V | V |
| Hypoxylon fragiforme | PP448059 | 7708 | A | Xylariales | IV | IV | IV |
| Hypoxylon rubiginosum | ON710968 | 7711 | A | Xylariales | V | V | V |
| Jackrogersella cohaerens | ON710957 | 7020 | A | Xylariales | I | II | I |
| Leptodontidium sp. | ON710921 | 6276 | A | Helotiales | V | V | V |
| Leptosillia muelleri | ON710931 | 6576 | A | Xylariales | II | II | II |
| Lopadostoma turgidum | ON710930 | 6575 | A | Xylariales | V | V | V |
| Lopadostoma turgidum | PP448045 | 6607 | A | Xylariales | V | V | V |
| Lophiostoma carpini | ON710946 | 6993 | A | Pleosporales | II | II | II |
| Lophiostoma carpini | PP448046 | 6994 | A | Pleosporales | V | V | V |
| Lophium arboricola | ON710911 | 6260 | A | Mytilinidiales | V | V | V |
| Melanomma populicola | ON710920 | 6274 | A | Pleosporales | V | V | V |
| Mucoromycota sp. | DNA extraction failed | 7022 | M | V | V | V | |
| Mycoarthris sp. | ON710925 | 6426 | A | Helotiales | V | V | V |
| Fungus sp. | DNA extraction failed | 6425 | V | V | V | ||
| Nectria cinnabarina | ON710894 | 6236 | A | Hypocreales | III | III | III |
| Nectria cinnabarina | PP448047 | 6239 | A | Hypocreales | III | III | III |
| Neocucurbitaria acerina | ON710909 | 6258 | A | Pleosporales | V | V | V |
| Neocucurbitaria acerina | PP448048 | 7204 | A | Pleosporales | IV | IV | IV |
| Neodidymelliopsis sp. | ON710913 | 6261 | A | Pleosporales | V | V | V |
| Neoleptosphaeria rubefaciens | ON710907 | 6255 | A | Pleosporales | V | V | V |
| Neonectria cf. ramulariae | ON710914 | 6264 | A | Hypocreales | IV | V | IV |
| Neonectria cf. ramulariae | PP448049 | 6265 | A | Hypocreales | V | V | V |
| Neonectria cf. ramulariae | ON786729 | 6273 | A | Hypocreales | IV | IV | IV |
| Neonectria sp. | ON710934 | 6582 | A | Hypocreales | II | II | II |
| Neosetophoma cf. italica | ON710903 | 6250 | A | Pleosporales | V | V | V |
| Neosetophoma cf. samarorum | PP448050 | 6277 | A | Pleosporales | I | I | I |
| Nigrograna cf. norvegica | ON710960 | 7189 | A | Pleosporales | II | II | II |
| Nigrograna mycophila | ON710943 | 6990 | A | Pleosporales | V | V | V |
| Paracamarosporium cf. fagi | ON710923 | 6420 | A | Pleosporales | I | II | II |
| Parapyrenochaeta protearum | ON710942 | 6989 | A | Pleosporales | V | V | V |
| Penicillium sp. | PP448051 | 6257 | A | Eurotiales | V | V | V |
| Petrakia irregularis | ON710932 | 6580 | A | Pleosporales | V | V | V |
| Pezicula sporulosa | ON710945 | 6992 | A | Helotiales | I | I | I |
| Pleosporales sp. | ON710922 | 6278 | A | Pleosporales | V | V | V |
| Porostereum spadiceum | ON710947 | 6997 | B | Polyporales | IV | IV | IV |
| Preussia cf. aemulans | ON710935 | 6585 | A | Pleosporales | I | I | I |
| Pseudogymnoascus cf. pannorum | ON710926 | 6428 | A | Thelebolales | V | V | V |
| Ramularia collo-cygni | ON710959 | 7023 | A | Mycosphaerellales | V | V | V |
| Serpula himantioides | ON710967 | 7710 | B | Boletales | II | II | II |
| Sordariomycetes sp. | ON710969 | 7712 | A | V | V | V | |
| Sordariomycetes sp. | ON710929 | 6572 | A | V | V | V | |
| Stereum cf. hirsutum | ON710916 | 6270 | B | Russuales | V | V | V |
| Thyridium vestitum | ON710904 | 6251 | A | Thyridiales | V | V | V |
| Tolypocladium sp. | ON710954 | 7010 | A | Hypocreales | II | II | II |
| Tolypocladium sp. | ON710961 | 7191 | A | Hypocreales | II | II | II |
| Trametes versicolor | ON710917 | 6271 | B | Polyporales | IV | IV | IV |
| Trichoderma cf. gelatinosum | PP448052 | 7705 | A | Hypocreales | V | V | V |
| Xenocylindrosporium | ON786728 | 6592 | A | Phaeomoniellales | V | V | V |
| Xylaria longipes | ON710890 | 6229 | A | Xylariales | V | V | V |
| Xylariales sp. | DNA extraction failed | 6341 | A | Xylariales | V | V | V |
List of all tested strains with taxonomic placement, NCBI accession number, and NW-FVA strain number, and results of Test 1; Cryptostroma corticale (CC), CC1: NW-FVA 5889, CC2: NW-FVA 7011 and CC3: NW-FVA 7148.
1A, Ascomycota; B, Basidiomycota; M, Mucoromycota; 2i.s., incertae sedis.
2.1 Test 1—Dual cultures on MYP
For the dual cultures of Test 1, 76 taxa with 102 strains were tested. For this test the method of Rigerte et al. (2019) was followed regarding set up and measurements (see Figure 2A). For each strain of C. corticale (CC1-CC3) triplicates per tested strain were set up. The inoculated Petri dishes were kept at room temperature and ambient light, and checked for growth on days three, five, and 10, each measured and marked on the back of the Petri dish. The cultures were measured along the two axes (alpha for the horizontal measurement and beta for the vertical measurement). The measurement stopped once mycelial contact was observed. If an overgrowth of one fungus over the other was observed an “NA” was noted in the measurements for that interaction (Supplementary Table 1). When both fungi met in a deadlock without overgrowth, the same measurements were noted for the following day of measurement since no additional growth was observed. On day 10, pictures were taken with a Nikon D3400 camera of one representative Petri dish out of each three replicates. The picture was later used for visual assessment and placement into the five different types of interaction I—V (Table 3), based on terms defined by Boddy (2000) and Badalyan et al. (2002).
Figure 2

Scheme of dual culture tests (a) between pathogen (yellow) and fungal potential antagonist (brown) (A) set-up for Test 1 and Test 2 with the pathogen (Cryptostroma corticale) on the left and the fungal potential antagonist on the right (Rigerte et al., 2019); (B) set-up for pathogen surrounded by six plugs of the fungal potential antagonist in Test 3; (C) interaction between pathogen (left) and the potential antagonist (right) for Test 4 with indication of re-isolation spots (Brglez et al., 2020).
Table 3
| Interaction type | Definition | Example | Scheme |
|---|---|---|---|
| I = B | Deadlock without contact |
C. corticale × Pezicula sporulosa |

|
| II = A | deadlock with contact, Petri dish not fully colonized by C. corticale |

C. corticale × Neonectria sp. |

|
| III = C | replacement of C. corticale by the potential antagonist |
C. corticale × Nectria cinnabarina |

|
| IV = A | deadlock, Petri dish fully colonised, recognition between the fungi visible through barrage |
C. corticale × Eutypa maura |

|
| V = C | replacement of the potential antagonist by C. corticale |
C. corticale × Neocucuritaria acerina |

|
Different types of interaction as defined in this study based on Boddy (2000) and Badalyan et al. (2002) with examples.
“A” deadlock at mycelial contact, “B” deadlock at distance without mycelial contact, and “C” replacement, meaning overgrowth without initial deadlock according to Badalyan et al. (2002).
The set-up of Test 1 was repeated after the initial results for all potential antagonists with at least one interaction in type I. The plugs of the potential antagonists were placed on the plate 1 week prior to the inoculation with C. corticale. The goal was to see whether the inhibition at a distance would become more prominent, if the potential antagonist had time to establish itself first.
Measuring data of Test 1 was analyzed using RStudio (V. 4.1.2, R Core Team, 2019; Supplementary Table 2) for statistical analysis following the first part of the script by Rigerte et al. (2019). For the R script analysis, the spherical index (alpha/beta) of the fungal growth was calculated. For this approach, it was assumed that a single pathogen on a Petri dish of medium would have a circular growth, i.e., have the same measurements for both alpha and beta, resulting in a spherical index of 1 (Rigerte et al., 2019). If this is true for single cultures, it follows that if the interaction continues in a dual culture setup, alpha and beta would not have the same value, resulting in a spherical index unequal to 1. An inhibition of the pathogen was detected in the data analysis, if the spherical index for the pathogen was smaller than 1 (growth on the alpha axis smaller than on the beta axis) and the spherical index for the endophyte on the dual assay was bigger than 1 (growth on the alpha axis higher than on the beta axis; Rigerte et al., 2019; Figure 3). In this study the control culture was set up with each tested fungus in a pairing against itself, also prepared in triplicates.
Figure 3

Illustration of the mean spherical indices of a set of a fungal endophyte antagonist plotted against their single test pathogen. This is a simulated dataset generated from a random distribution (n = 100, mean = 1, standard deviation = 0.5) that mimics empirical data observed in this experiment. Data points colored green are instances with possible antagonistic interaction while red data points indicate non-antagonistic interactions; created with the R-script published by Rigerte et al. (2019, R V4.1.2).
2.2 Test 2—Dual cultures on MYP and PDA at 25°C
For specific investigation of the fungi which had at least one interaction against C. corticale classified as type I, the set-up of Test 1 was repeated with two different types of media for Test 2, i.e., MYP and PDA at 25°C. For each pairing of C. corticale with the respective antagonist, three replicates were prepared following the procedure of Test 1. The Petri dishes were stored in a Binder KBW240 climate chamber at 25°C and ambient daylight for 10 days, measured three times, as described for Test 1, and photographed on day 10. In total, nine strains which had at least one interaction classified as type I were tested.
2.3 Test 3—One plug of C. Corticale against six plugs of the potential antagonist
The strains tested in Test 3 had at least one interaction classified as type I, II, or III in Test 1 and 2. A total of 22 strains were tested against C. corticale (Table 4). An experimental set up was designed where the C. corticale plug was placed in the middle of the Petri dish, surrounded by six plugs colonized by the potential antagonist (Figure 2B), which were placed at a distance of 3 cm to C. corticale. Strains observed to grow much slower than C. corticale, namely Beauveria pseudobassiana S.A. Rehner & Humber, Cadophora prunicola (strain NW-FVA 6996) Damm & S. Bien, Calosporella innesii (Curr.) J. Schröt., Diaporthe pustulata Sacc., Hypholoma fasciculare (Huds.) P. Kumm., Jackrogersella cohaerens (Pers.) L. Wendt, Kuhnert & M. Stadler, Leptosillia muelleri (Duby) Voglmayr & Jaklitsch, Lophiostoma carpini Andreasen, Jaklitsch & Voglmayr (strain NW-FVA 6993), Neonectria sp., Neosetophoma cf. samarorum, Paracamarosporium cf. fagi, Pezicula sporulosa Verkley, Preussia cf. aemulans, Serpula himantioides (Fr.) P. Karst, Tolypocladium sp. (strain NW-FVA 7010 and 7,191) and a coelomycete (NW-FVA 7709) were placed on the test Petri dish 1 week prior to C. corticale, to give them time to establish themselves before the inoculation of the fast-growing C. corticale. After ten days each interaction was evaluated and again categorized into one of the five interaction types.
Table 4
| Taxon | NW-FVA ID | Dual culture –Test 1 | Growth challenge between C. corticale and 6 plugs of the potential antagonist - Test 3 | Viability of CC hyphae in -Test 4 | ||||
|---|---|---|---|---|---|---|---|---|
| CC1 | CC2 | CC3 | CC1 | CC2 | CC3 | |||
| Apiospora cf. marii | 7,004 | V | V | IV | ||||
| Apiospora cf. marii | 7,013 | IV | IV | IV | ||||
| Apiospora kogelbergensis | 7,713 | IV | IV | IV | ||||
| Beauveria pseudobassiana* | 6,581 | I | I | I | I | I | I | 50% |
| Biscogniauxia nummularia | 6,227 | IV | IV | IV | ||||
| Cadophora prunicola* | 6,996 | I | I | II | I | I | I | 50% |
| Calosporella innesii* | 6,573 | II | II | II | II | II | II | 83% |
| Cephalotrichum sp. | 6,247 | V | I | II | V | V | V | 100% |
| Clonostachys rosea | 6,243 | II | II | II | IV | IV | IV | 100% |
| coelomycete* | 7,709 | V | V | II | V | V | V | 100% |
| Coprinellus sp. | 7,000 | III | III | III | ||||
| Diaporthe cf. eres | 7,714 | IV | V | V | ||||
| Diaporthe pustulata* | 6,228 | II | II | II | II | II | II | 83% |
| Didymellaceae sp. | 6,998 | IV | IV | IV | ||||
| Eutypa maura | 6,245 | IV | IV | IV | ||||
| Eutypa maura | 7,018 | IV | IV | IV | ||||
| Eutypa cf. petrakii var. hederae | 6,267 | V | V | IV | ||||
| Eutypella quaternata | 6,238 | II | II | II | IV | IV | IV | -b |
| Hypholoma fasciculare* | 6,241 | II | I | II | I | I | I | 50% |
| Hypoxylon fragiforme | 7,707 | IV | V | V | ||||
| Jackrogersella cohaerens* | 7,020 | I | II | I | I | I | I | 50% |
| Leptosillia muelleri* | 6,576 | II | II | II | II | II | V | -b |
| Lophiostoma carpini | 6,993 | II | II | II | V | V | V | -b |
| Nectria cinnabarina | 6,236 | III | III | III | III | III | III | |
| Nectria cinnabarina | 6,239 | III | III | III | III | III | III | |
| Neocucurbitaria acerina | 7,204 | IV | IV | IV | ||||
| Neonectria cf. ramulariae | 6,264 | IV | V | IV | ||||
| Neonectria cf. ramulariae | 6,273 | IV | IV | IV | ||||
| Neonectria sp.* | 6,582 | II | II | II | IV | IV | I | 33% |
| Neosetophoma cf. samarorum* | 6,277 | I | I | I | V | IV | II | 100% |
| Nigrograna cf. norvegica | 7,189 | II | II | II | –a | –a | –a | –a |
| Paracamarosporium cf. fagi* | 6,420 | I | II | II | I | I | I | 50% |
| Pezicula sporulosa* | 6,992 | I | I | I | I | I | I | 50% |
| Porostereum spadiceum | 6,997 | IV | IV | IV | ||||
| Preussia cf. aemulans* | 6,585 | I | I | I | I | I | I | 83% |
| Serpula himantoides* | 7,710 | II | II | II | I | I | I | 67% |
| Tolypocladium sp.* | 7,191 | II | II | II | I | I | I | 83% |
| Tolypocladium sp.* | 7,010 | II | II | II | I | I | I | 100% |
| Trametes versicolor | 6,271 | IV | IV | IV | ||||
Observed interaction types (I-V) in the dual culture of the potential antagonists against Cryptostroma corticale for Test 1 and Test 3.
*The antagonist was placed onto the petri dish 1 week prior to C. corticale in Test 3. aStrain was not viable anymore when tests were conducted. bC. corticale overgrew culture of potential antagonist, no sampling of single hyphae was possible. For the tests different Cryptostroma corticale (CC) strains were used (CC1: NW-FVA 5889, CC2: NW-FVA 7011 and CC3: NW-FVA 7148), empty cell: not tested; total percentage of viable hyphae for Test 4; strains that were exclusively Type V are not shown.
2.4 Test 4—Viability test of hyphae
The setup of Test 1 was repeated for Test 4 (see Table 4). Twenty strains with interactions categorized into type I, or II were tested. The aim was to see whether C. corticale hyphae were still viable after the hyphal growth on the Petri dish stopped or if the hyphal tips had died and thus stopped growing. After 10 days two areas of the C. corticale culture were examined by transferring a 2 mm piece of a single hypha from different spots of the interaction zone. One piece was taken from the side of the interaction zone and one from the middle of the interaction zone, permitted the mycelia had no contact (Figure 2C). The taken pieces were transferred onto an additional new medium Petri dish, respectively, according to Brglez et al. (2020). If the fungi had grown into each other, one sample was taken from each of the two side margins of the culture, where no mycelial contact was observed. The hyphae were sampled under a Stereomicroscope (ZEISS Stemi 508) to ensure that only one hyphal tip was sampled.
We considered those strains as potential antagonists that had the majority of their tested interactions with C. corticale placed in type I and the remaining interactions in no less than type II. Potential antagonists, which were considered for further testing were reconsidered after each test. An antagonism was considered “stronger” or “more prominent” when the distance between the two fungal cultures was larger than in a previous test. For some taxa multiple strains were available and tested. Ultimately, fungi which had consistent antagonistic results over all conducted tests were chosen as potential antagonists. The fungi classified as type III were not considered as potential antagonists since the interaction between the two fungi could not be undoubtedly classified.
3 Results
3.1 Test 1—Dual cultures on MYP and statistical analysis
All 102 tested strains, comprising 76 fungal taxa, were grouped as types based on Test 1. The detailed results for the 39 strains classified as type I-IV can be found in Table 4. The remaining 63 strains, which are not shown in this table had all interactions placed into type V and can be found in Table 2. In total 918 interactions were evaluated. For four of the tested taxa a deadlock without contact was observed against all C. corticale strains, thus classifying them as type I. These were B. pseudobassiana, N. cf. samarorum, P. sporulosa, and Pr. cf. aemulans. Eleven strains were classified as type II, exhibiting signs of inhibition against C. corticale. The strains categorized as type II are Cal. innesii, Clonostachys rosea (Link) Schroers, Samuels, Seifert & W. Gams, D. pustulata, Eutypella quaternata (Pers.) Rappaz, L. muelleri, Lo. carpini (strain NW-FVA 6993), Neonectria sp., Nigrograna cf. norvegica, S. himantioides, and Tolypocladium sp. (strains NW-FVA 7010 and NW-FVA 7191). Three strains were categorized as type III, Coprinellus sp. and two strains of Nectria cinnabarina (Tode) Fr. (strains NW-FVA 6236 and NW-FVA 6239). Eleven strains were categorized as type IV, and 63 strains were categorized as type V (see Table 2).
Four of the tested strains, C. prunicola (strain NW-FVA 6996), H. fasciculare, Pa. cf. fagi, and J. cohaerens showed different interactions with each of the three C. corticale strains and were classified as either type I or type II. The remaining 11 strains had to be placed into more than one category regarding the interactions with the different strains of C. corticale (see Tables 2 and 4). For Cephalotrichum sp. (NW-FVA 6347) the interactions with the three different strains of C. corticale were all placed in different interaction types (CC1 type V, CC2 type I, and CC3 type II).
Ninety-nine of the tested strains had a slower or similar growth rate as C. corticale and 61 (type V) of them were overgrown by C. corticale. Three species tested in this study had a faster growth than C. corticale. Of the 13 taxa with multiple strains tested, only repeat strains of seven taxa were categorized into the same type for their interactions with all three C. corticale strains. Six of which were categorized as type V, while N. cinnabarina was categorized as type III. For C. prunicola strain NW-FVA 6996 the interaction with CC1 was classified as type II and the CC2 and CC3 interactions as type I. In comparison all interactions of C. prunicola strain NW-FVA 6596 were categorized as type V. Similar results were observed for Lo. carpini strain NW-FVA 6993 and NW-FVA 6994.
The results of the re-tested type I fungi, which were placed on the Petri dish 1 week prior to inoculation with C. corticale (Supplementary Table 3) show a more prominent antagonism at a distance for six of the nine tested strains than those of the original Test 1. For those six strains it is visible, that C. corticale is unable to grow forwards. This is most prominent for P. sporulosa and Pr. cf. aemulans. For Cephalotrichum sp., Neosetophoma cf. samarorum and J. cohaerens no antagonism at a distance could be observed. For H. fasciculare an inhibition at a distance could only be observed for CC2 and CC3. CC1 had mycelial contact with the potential antagonist, though the plate was not fully colonized (type II).
According to the results of the analysis of the spherical indices from Test 1 (Figures 4A–C), CC1 expressed a slower growth than against itself in the pairings with four of the potential antagonists. Of these pairings three were classified as type I, while one was classified as type II. CC2 showed a slower growth than in a pairing against itself against five potential antagonists. Four interactions of these pairings were classified as type I, one interaction was classified as type II. Compared to a pairing against itself, CC3 showed a slower growth when paired against six of the potential antagonists. Out of these only three interactions were classified as type I, the remaining interactions were classified as type II.
Figure 4

Results of the of the mean spherical indices from Test 1 shown for the day 10 measurements, separated by Cryptostroma corticale strain showing the interactions with potential antagonism in the lower right quadrant, Cryptostroma corticale (CC), (A) CC1: NW-FVA 5889, (B) CC2: NW-FVA 7011, (C) CC3: NW-FVA 7148. The potentially antagonistic interactions for each strain are labeled with the individual interaction abbreviations (NW-FVA number antagonist_NW-FVA number C. corticale strain).
In total 19 strains were classified as type I, type II, or a combination of the two, and subsequently as potential antagonists to be investigated in the following tests (Table 4).
3.2 Test 2—Dual culture on MYP and PDA at 25°C
In Test 2, the fungi that previously exhibited an interaction classified as type I against at least one C. corticale strain, showed variation between types of media. The antagonistic reaction was more prominent and stronger on PDA than on MYP at a temperature of 25°C for all stains except Cephalotrichum sp. (NW-FVA 6247; see Supplementary Table 3). After the tenth day of incubation at 25°C, differences in growth rate and observed antagonism on MYP could be observed for some of the tested fungi compared to the tests at room temperature (see Table 5 and Supplementary Table 3). Three strains had a visibly slower growth at 25°C than at room temperature against themselves. The interactions between H. fasciculare and CC2 and CC3 were more prominent at 25°C. In both, N. cf. samarorum and Pa. cf. fagi, all combinations had mycelial contact without the Petri dish being fully colonized, so they were classified as type II and not as type I as at room temperature. For Pr. cf. aemulans all interactions were classified as type I, confirming the results of Test 1. However, the C. corticale cultures stopped growing in a straight line at 25°C, while those at room temperature continued to colonize the Petri dish, growing in a half circle, as shown in Table 3 for type I. Cephalotrichum sp. did not show an antagonistic reaction against CC2 in Test 2 on neither of the tested media and interacted according to type V, not confirming the observations from Test 1.
Table 5
| Name | NW-FVA number | CC1 | CC2 | CC3 | ||||||
|---|---|---|---|---|---|---|---|---|---|---|
| MYP | MYP 25°C | PDA 25°C | MYP | MYP 25°C | PDA 25°C | MYP | MYP 25°C | PDA 25°C | ||
| Beauveria pseudobassiana | 6581 | I | II | II | I | II | II | I | II | II |
| Cadophora prunicola | 6996 | II | V | II | I | V | II | I | II | I |
| Cephalotrichum sp. | 6247 | V | V | V | I | V | V | II | V | V |
| Hypholoma fasciculare | 6241 | II | II | I | I | I | I | II | I | I |
| Jackrogersella cohaerens | 7020 | I | I | I | II | I | I | I | I | I |
| Neosetophoma cf. samarorum | 6277 | I | II | II | I | II | II | I | II | II |
| Paracamarosporium cf. fagi | 6420 | I | II | I | II | II | I | II | II | I |
| Pezicula sporulosa | 6992 | I | II | I | I | I | I | I | I | I |
| Preussia cf. aemulans | 6585 | I | I | I | I | I | I | I | I | I |
Results of Test 2 shown for comparison for nine promising potential fungal antagonists fungi identified in Test I and II; MYP: Malt Yeast Peptone Agar, PDA: Potato Dextrose Agar, Cryptostroma corticale (CC), CC1: NW-FVA 5889, CC2: NW-FVA 7011 and CC3: NW-FVA 7148.
3.3 Test 3—One plug of C. Corticale against six plugs of the potential antagonist
For three out of the four fungi classified as type I, the initially observed interaction type from Test 1 was confirmed in Test 3 (Table 4). For N. cf. samarorum the interaction type could not be confirmed for CC2 in this test, for CC3 the interaction type appears to be confirmed for four of the six mycelium plugs placed. In this interaction, C. corticale was able to advance to mycelial contact with the remaining two mycelium plugs, but was not able to overgrow them during the 10-day observation. Out of the 11 type II fungi the growth challenge was conducted for 10. Nigrograna cf. norvegica was not viable anymore at the time of testing. Out of these 10 the interaction for three strains, S. himantoides, and cf. Tolypocladium sp. (strains NW-FVA 7010 and 7,191), could be classified as type I and the interaction according to type II was confirmed for two other strains (Cal. innesii and D. pustulata). The interaction in the growth challenge was classified into type IV for Clonostachys rosea and E. quaternata, and into type V for Lo. carpini. For the three remaining type II strains tested, the results differed among the three C. corticale strains. C. prunicola strain NW-FVA 6996, H. fasciculare and P. cf. fagi had their interactions in Test 3 classified into type I, respectively, as opposed to a mix of type I and II in Test 1. Strain NW-FVA 7709 (coelomycete), as well as Cephalotrichum sp. had all three interactions of Test 3 were classified into type V, thus not showing any antagonistic interaction. For both N. cinnabarina strains the reaction according to type III was confirmed.
3.4 Test 4—Viability test of hyphae
Of the 102 hyphal samples taken from C. corticale, 74 (73%) were still viable. From five of the 20 potentially antagonistic strains tested, all the examined hyphae of C. corticale were still able to grow after being transferred to a new MYP-Petri dish (Tables 4 and 6). For the interactions between the three C. corticale strains and H. fasciculare only the samples taken from the side were viable. Out of the four type I fungi, all six samples taken from N. cf. samarorum were taken from the side and were still viable. Whereas for both B. pseudobassiana and P. sporulosa one sample from the middle and one sample from the side margin of every Petri dish was taken, while only the samples from CC1 were both still viable. For both of these strains one of the CC2 samples was still viable, for B. pseudobassiana the sample from the side margin and for P. sporulosa the sample taken from the middle. All four samples taken from the interaction with CC3 were not viable anymore. Five out of six samples taken from Pr. cf. aemulans were still viable. Here, also equal samples of middle and side margin were taken. The only sample not viable anymore from this strain was the sample taken from the middle of the interaction with CC1. No samples of C. corticale could be taken from pairings with E. quaternata, L. muelleri and Lo. carpini, because C. corticale had overgrown the potential antagonist.
Table 6
| No. of hyphal samples taken from the middle of the C. corticale culture | Viable (%) | No. of hyphal samples taken from the side margin of the C. corticale culture | Viable (%) | Hyphal samples viable in total | |
|---|---|---|---|---|---|
| CC1 | 9 | 4 (44%) | 25 | 19 (76%) | 23 (68%) |
| CC2 | 11 | 7 (64%) | 23 | 21 (91%) | 28 (82%) |
| CC3 | 10 | 2 (20%) | 24 | 21 (88%) | 23 (68%) |
| Sum | 30 | 13 (43%) | 72 | 61 (85%) | 74 (73%) |
Results of Test 4, where the viability of hyphal samples was tested; Cryptostroma corticale (CC), CC1: NW-FVA 5889, CC2: NW-FVA 7011, CC3: NW-FVA 7148.
4 Discussion
Throughout the experimentation process, the number of potential antagonists identified in Test 1 decreased with each subsequent test. Ultimately, strains of five fungal species demonstrated the most consistent potential as antagonists against C. corticale due to their inhibitory effects across all four tests, and will be discussed hereinafter.
Hypholoma fasciculare commonly colonizes logs of beech wood, as well as the wood of other broad-leaved tree species (Coates and Rayner, 1985) and has also been reported as a saprophyte causing white rot in roots and tree trunks (Folman et al., 2008; Šnajdr et al., 2011). It has previously been reported that H. fasciculare possesses antagonistic properties against other fungi (e.g., Badalyan et al., 2002) and has already been described as a potential BCA against Armillaria ostoyae Romagn. (Herink) in North America (Chapman and Xiao, 2000; Stevens et al., 2020). Species of the genus Hypholoma can also be found in the soil and decomposing litter in forests (Thompson et al., 2012).
Jackrogersella cohaerens, as well as many other fungi belonging to the family of the Hypoxylaceae (Wendt et al., 2018), are known to be common endophytes of woody tissue, and can be beneficial to the host (Halecker et al., 2020; Langer and Bußkamp, 2021; Song et al., 2022). Jackrogersella cohaerens primarily colonizes dead or dying beech wood and can be a saprophyte on beech (Sinclair and Lyon, 2005). It has been described as a colonizer of beech and less frequently maple (Sinclair and Lyon, 2005), and can cause disease in beech trees (Schumacher et al., 2006). As J. cohaerens can cause disease on beech, it would be important to test whether it could potentially cause disease on sycamore as well, especially since the strain tested was isolated from discolored and decaying wood of A. pseudoplatanus by Schlößer et al. (2023).
Paracamarosporium cf. fagi is a fungus belonging to the Pleosporales. The first report was made from twigs of Fagus sylvatica L. (Crous et al., 2015). It is a Coniothyrium-like species and is described to also appear on Betula pendula Roth, Elaeagnus rhamnoides L., and was found saprobic on twigs of Ziziphus jujube Mill (Hyde et al., 2020). It has been reported from Germany, the Republic of Latvia and Ukraine (Crous et al., 2015; Hyde et al., 2020). Other fungi of the genus Coniothyrium, i.e., Coniothyrium minitans, have been described as potential BCAs (e.g., Whipps and Gerlagh, 1992; De Vrije et al., 2001).
Pezicula sporulosa has been described as an endophyte on Abies beshanzuensis Wu. (Yuan et al., 2011). Other Pezicula species also appear as endophytes in several different coniferous and broadleaved trees (Noble et al., 1991; Kehr, 1992; Kowalski and Kehr, 1992; Schulz et al., 1995; Langer et al., 2021). Simultaneously, P. sporulosa can cause canker disease on various species of coniferous and broadleaved trees in Europe (Rossman et al., 2018). Nevertheless, several Pezicula species possess antifungal properties (Noble et al., 1991; Schulz et al., 1995). A recent study showed that a strain of Pezicula cf. ericae has antagonistic properties against the causal agent of ash dieback, Hymenscyphus fraxineus (T. Kowalski) Baral, Queloz & Hosoya (Demir et al., 2023).
Preussia aemulans (Rehm) Arx is known as an endophyte and saprotroph (Domsch et al., 1980 as cited in Elmholt and Kjøller, 1989; Gonzalez-Menendez et al., 2017). The genus Preussia contains several endophytic species (Arenal et al., 2007; Porras-Alfaro et al., 2014; Massimo et al., 2015) but is also generally known to occur on leaf litter, dung or in soil (Cain, 1961; Rai and Tewari, 1963; Peterson et al., 2009; Asgari and Zare, 2010). Some strains of the genus Preussia have also been described to have antifungal/antimicrobial properties (Weber and Gloer, 1988, 1991; Mapperson et al., 2014; Motlagh and Usefipoor, 2016; Perlatti et al., 2021).
4.1 Test 1—Dual cultures on MYP and statistical analysis
Test 1 revealed that C. corticale often overgrew potential antagonists due to its rapid growth compared to most fungi. Given that C. corticale has a higher growth rate than the majority of fungi in our study, it appears to have an advantage over these slow-growing fungi in terms of colonizing tissue. Six of the re-tested type I strains, which were placed on the Petri dish 1 week prior to C. corticale, exhibited a more prominent antagonism than observed in the original Test 1. This could indicate that organic compounds were released into the growth media by the potential antagonists, creating a stronger antagonistic reaction (Boddy, 2016). Similar results were demonstrated by Sonnenbichler et al. (1994) and recently shown for antagonism assays between H. fraxineus and an endophyte isolated from F. excelsior by Demir et al. (2023). This information can be used for further investigation into a potential control for C. corticale.
The majority of the fungi tested showed the same response in the three replicates and pairings with the three different C. corticale strains. However, for some tested fungal strains one or more of the replicates showed different results and the results varied strongly between the three C. corticale strains. The various interactions with the different C. corticale strains were therefore categorized into different interaction types, as evident for Cephalotrichum sp. (NW-FVA 6247). It has previously been observed, that the fungus-fungus interaction can vary in some cases between the same fungi, even under seemingly identical conditions (Rayner et al., 1994; Boddy, 2000; Brglez et al., 2020). This might be a factor in the differences observed between the interactions with the individual C. corticale strains.
The statistical analysis of the measurements of Test 1 simply represents the growth of each individual fungus by its respective spherical index. Consequently, the data analysis does not reflect the interaction between the fungi, i.e., replacement or deadlock. The spherical index of the fungal growth does not account for the space left in between the fungi, since it only analyses the growth of one of the two fungi. This aspect was also critically stated by Rigerte et al. (2019) in the original methodology. Observation of distance left between the tested fungi on the last day of measurement was a valuable characterization for detecting potential antagonisms, allowing us to detect 19 potential antagonists (type I and II) from Test 1.
4.2 Test 2—Dual culture on MYP and PDA at 25°C
In Test 2, C. corticale appeared to be more competitive growing on MYP at 25°C, its optimal growing temperature (Dickenson, 1980), than at room temperature. For all but one strain the interaction was more prominent on PDA than on MYP at 25°C. As described in several other studies, different types of artificial media affect the growth rates and habitus of fungal cultures (Botella et al., 2016), mycelial interactions between fungi (Brasier and Webber, 2013) as well as the production of antibiotics and a fungus’ response to these antibiotics (Whipps, 1987). These findings account for differences in interaction as well as variance in the morphology of fungi on different artificial media, as observed for J. cohaerens. Furthermore, it was observed that some fungi, which were originally classified as interaction type II in Test 1, were classified into type I in Test 2. On the other hand, a switch from interaction type I to type II was also observed. The different behavior is likely a result of the different temperature, as compared to Test 1.
4.3 Test 3—One plug of C. Corticale against six plugs of the potential antagonist
Test 3 clarified the previous observations made in Test 1 and 2 (Table 4 and Supplementary Table 3). No antagonism was observed for coelomycete (NW-FVA 7709) in Test 3, but interestingly, the culture habitus of C. corticale in this pairing differed from its normal appearance in pure culture. This suggests that there was some kind of interaction between the coelomycete and C. corticale altering the mycelial growth of the latter. Similar observations have been made by Donnelly and Boddy (2001) for H. fasciculare and Agrocybe gibberosa (Fr.) Fay. when placed against Stropharia caerulea (Kriesel). Cephalotrichum sp. (NW-FVA 6247) was the only fungus where all three interactions with the different C. corticale strains were placed into different types in this study, and no antagonism could be observed in Test 3. All interactions from Test 3 for Cephalotrichum sp. were classified as type V, showing no antagonistic properties against any of the tested C. corticale strains. One possible explanation for these inconsistent results observed from Cephalotrichum sp. is that there is a difference between the three C. corticale isolates used in Test 1, which only specifically affects Cephalotrichum sp. Another possible explanation for the change in behavior of Cephalotrichum sp. might be the fact that Test 1 and 2 were conducted the same year the fungi were isolated. Test 3 and 4 were conducted one and a half years later, after the fungi had been stored in the fungal collection in tubes with MYP media at +4°C. As Humber (1997) and Butt and Copping (2000) state, fungi kept on artificial medium, especially after serial transfer, can lose their antagonistic characteristics, as observed for six of the tested strains. To reduce the loss of competitiveness and antagonistic properties of fungi, one solution is to periodically change the growth medium or even periodically transfer the fungus to suitable sterile host material (Marx and Daniel, 1976; Thomson et al., 1993). As a standard procedure conducted in this study, a transfer between different nutrient media was done for each strain after taking them out of the collection. After being stored on MYP the fungi were transferred to Malt-Extract-Agar according to Bußkamp (2018) for a week and then transferred back to MYP to prepare the cultures for the experiment. Nevertheless, this does not exclude the loss or weakening of certain traits (Tables 5, 6).
4.4 Test 4—Viability test of hyphae
In Test 4 it was found that 73% of the tested hyphae of C. corticale were capable of growth when re-cultivated on new artificial medium, even though C. corticale no longer showed growth in the original dual culture with the potential antagonist. Similar results were reported by Brglez et al. (2020), who found that after deadlock at distance the sampled hyphae of the tested pathogen, E. quaternata (Pers.) Rappaz, grew out eight out of 10 times. This indicates that although the growth of C. corticale was inhibited by the antagonist, it is still viable and able to colonize fresh nutrient medium, suggesting a fungistatic effect. Possibly, there were inaccuracies in cutting the hyphal pieces from the dual culture when extracting dead hyphal cells next to still living hyphae. However, it is possible that through organic compounds emitted by the potential antagonist, the pathogen might be inhibited in its growth and thus unable to colonize the uncultured media. Baptista et al. (2021), for example, state that many of the secondary metabolites produced by H. fasciculare are known to have antimicrobial effects. Also for P. sporulosa the production of antifungal secondary metabolites is known (McMullin et al., 2017). Some of these secondary metabolites can cause mortality of fungi, as described for a combination of beauvericin and ketoconazole against Candida parapsilosis (Ashford) Langeron & Talice by Wang and Xu (2012).
4.5 General discussion
Dual culture tests on artificial media, such as those used in this study, are useful for observing interactions between fungi, but do not consider the complexity of interactions in vivo. The results of antagonism tests have been shown to differ significantly between in vitro and in vivo antagonism tests (Dowson et al., 1988; Woods et al., 2005; Peters et al., 2020). The same applies to the differences between greenhouse and field trials (Heydari and Pessarakli, 2010). Still, in vitro antagonism tests are necessary and useful to gain an insight into fungal interactions previous to in vivo tests. The growing rate in vivo might differ from the growing rate in vitro for both C. corticale and the potential antagonists. The growing rate of C. corticale in vivo is insufficiently researched. The results obtained by Alcock and Wheeler (1983) show though, that the in vivo growth rate of C. corticale appears to depend more on the host factor than the isolate itself. This makes it hard to predict the in vivo interaction, which can differ quite significantly from in vitro observations (e.g., Lundborg and Unestam, 1980; Raziq and Fox, 2003).
One possible explanation for the observed inconsistencies in antagonistic behavior, as described above for, e.g., Cephalotrichum sp., is that most of the tested fungi might utilize a different carbon source than C. corticale and additionally might not naturally be antagonistic. Oliva et al. (2021) showed that the mycobiome of pine trees changes after hail damage and demonstrated that different fungi grow differently on different media, suggesting that they use different carbon sources. Another factor that may be relevant is that C. corticale is not a native fungus of Central Europe. Due to its recent introduction in an evolutionary time frame and the lack of time for coevolution with other fungi (Prospero et al., 2021) or with the host species itself, it is possible that there are no true natural antagonists in Europe despite its presence in Germany since the 1960s. The observation that C. corticale overgrew most of the tested fungi adds to the assumption that it is very competitive, underlining the need for an effective and strong antagonist.
It would be necessary to investigate if H. fasciculare, J. cohaerens, Pa. cf. fagi, P. sporulosa, and Pr. cf. aemulans can cause symptoms on A. pseudoplatanus and, if so, what kind of symptoms are caused. Following the results of such an experiment, it could be decided whether the infection with the potential antagonist is more beneficial than with C. corticale. Considering that H. fasciculare can cause white rot, it is not an ideal candidate for a BCA. As an alternative to using a living organism, which can be unpredictable and could cause symptoms itself, it could be beneficial to get an understanding of the secondary metabolome of the five potential antagonists identified in this study. It is possible that secondary metabolites play a role in the inhibition of C. corticale (Woodward and Boddy, 2008). Such organic compounds with antimicrobial and antifungal properties have been identified for two of the five potential antagonists, namely H. fasciculare and P. sporulosa (McMullin et al., 2017; Baptista et al., 2021). For a wide use as a BCA, it is relevant for the potential antagonist to be effective against any strain of C. corticale, which could be encountered in a plant. This could also be resolved by using secondary metabolites instead of living organisms. Since trees are perennial plants, as opposed to annual crops, it would be beneficial for a biological control measure for trees to be effective over several years. Depending on the pathogen, the development of a disease in woody tissues may take longer than one growing season. Since many pathogens persist in the host for several years (Prospero et al., 2021) they require long-term control. It is also important to consider the time of year a pathogen first infects the plant, the plant tissue the pathogen mainly infects, and how the interaction between pathogen and antagonist develops in time and space (Heydari and Pessarakli, 2010). The time of plant infection is crucial for the successful establishment of the pathogen within the plant (Rodriguez and Redman, 1997). For biological control to be effective, the antagonistic fungus has to establish itself in the plant in order to be effective as a preventative rather than a curative measure (Heydari and Pessarakli, 2010). Several factors have to be considered for a biological control in a forest pathosystem in comparison to the application in agricultural systems, e.g., a more complex anatomy of trees than crops, a longer lifespan of trees, and a lack of regular plant rotation, which can reduce the levels of potential inoculum (Cazorla and Mercado-Blanco, 2016). Treating forest stands with biological control agents could be more challenging than treating trees in urban settings. The number of plants that would need to be treated alone poses a challenge in terms of manpower and the potential for periodic treatment renewal.
5 Conclusion and outlook
This study can provide a basis for further research into potential antagonists against C. corticale. Out of the 102 fungal strains associated with sycamore tested, we were able to identify five promising potential antagonists against C. corticale, namely H. fasciculare, J. cohaerens, Pa. cf. fagi, Pr. cf. aemulans, and P. sporulosa. These fungi appear to have a certain potential as biological controls in vitro. Prior to in planta experiments with both C. corticale and the potential antagonist, pathogenicity tests with the potential antagonists should be carried out on A. pseudoplatanus to ensure their harmlessness to the tree when used in an infection set-up. The next step, in order to find biological control against C. corticale, should be to test these most promising antagonists in planta, e.g., in greenhouse experiments. This could be done by using dual infections in young sycamore trees to see if the responses observed in vitro could be extrapolated to the in vivo interaction in host plants.
Statements
Data availability statement
The datasets presented in this study can be found in online repositories. The names of the repository/repositories and accession number(s) can be found in the article/Supplementary material.
Author contributions
RS: Conceptualization, Data curation, Formal analysis, Investigation, Methodology, Writing – review & editing, Writing – original draft. SB: Conceptualization, Methodology, Writing – review & editing. JB: Conceptualization, Methodology, Writing – review & editing. GL: Conceptualization, Funding acquisition, Investigation, Project administration, Resources, Supervision, Writing – review & editing. EL: Supervision, Writing – review & editing.
Funding
The author(s) declare that financial support was received for the research, authorship, and/or publication of this article. The project in which this study was conducted was funded by the Hessian Ministry of the Environment, Climate Protection, Agriculture, and Consumer Protection and located at the Northwest German Forest Research Institute (NW-FVA). The funding for the publication costs was provided by the Open Access Fund of the University of Kassel.
Acknowledgments
The authors thank Annette Ihlemann, Martina Hille and Brigitte Jünemann for their technical support in the laboratory, and Maia Ridley for proofreading the manuscript as a native speaker. Additionally, the authors would like to thank Holger Sennhenn-Reulen for his support aiding the statistical analysis and Etta Starick for her help regarding the graphics. Thanks also go to the reviewers and the editor for their valuable recommendations to improve the manuscript.
Conflict of interest
The authors declare that the research was conducted in the absence of any commercial or financial relationships that could be construed as a potential conflict of interest.
Generative AI statement
The authors declare that no Gen AI was used in the creation of this manuscript.
Publisher’s note
All claims expressed in this article are solely those of the authors and do not necessarily represent those of their affiliated organizations, or those of the publisher, the editors and the reviewers. Any product that may be evaluated in this article, or claim that may be made by its manufacturer, is not guaranteed or endorsed by the publisher.
Supplementary material
The Supplementary material for this article can be found online at: https://www.frontiersin.org/articles/10.3389/ffgc.2024.1518972/full#supplementary-material
References
1
Alcock S. Wheeler B. E. J. (1983). Variability of Cryptostroma corticale, the causal fungus of sooty bark disease of sycamore. Plant Pathol.32, 173–176. doi: 10.1111/j.1365-3059.1983.tb01316.x
2
Arenal F. Platas G. Pelaez F. (2007). A new endophytic species of Preussia (Sporormiaceae) inferred from morphological observations and molecular phylogenetic analysis. Fungal Divers.25, 1–17.
3
Asgari B. Zare R. (2010). Two new species of Preussia from Iran. Nova Hedwigia90, 533–548. doi: 10.1127/0029-5035/2010/0090-0533
4
Badalyan S. M. Innocenti G. Garibyan N. G. (2002). Antagonistic activity of xylotrophic mushrooms against pathogenic fungi of cereals in dual culture. Phytopathol. Mediterr.41, 220–225. doi: 10.1400/14513
5
Baptista P. Guedes De Pinho P. Moreira N. Malheiro R. Reis F. Padrão J. et al . (2021). In vitro interactions between the ectomycorrhizal Pisolithus tinctorius and the saprotroph Hypholoma fasciculare fungi: morphological aspects and volatile production. Mycology12, 216–229. doi: 10.1080/21501203.2021.1876778
6
Bastos A. Fu Z. Ciais P. Friedlingstein P. Sitch S. Pongratz J. et al . (2020). Impacts of extreme summers on European ecosystems: a comparative analysis of 2003, 2010 and 2018. Philos. Trans. R. Soc. B375:20190507. doi: 10.1098/rstb.2019.0507
7
Boddy L. (2000). Interspecific combative interactions between wood-decaying basidiomycetes. FEMS Microbiol. Ecol.31, 185–194. doi: 10.1111/j.1574-6941.2000.tb00683.x
8
Boddy L. (2016). “Interactions between Fungi and other microbes” in The Fungi. eds. CarlileM. J.WatkinsonS. C.GoodayG. W. (Amsterdam: Elsevier), 337–360.
9
Botella L. Čermáková V. Bačová A. Dvořák M. (2016). ADA, a fast-growth medium for Hymenoscyphus fraxineus. For. Pathol.46, 85–87. doi: 10.1111/efp.12251
10
Brasier C. Webber J. (2013). Vegetative incompatibility in the ash dieback pathogen Hymenoscyphus pseudoalbidus and its ecological implications. Fungal Ecol.6, 501–512. doi: 10.1016/j.funeco.2013.09.006
11
Braun M. Klingelhöfer D. Groneberg D. A. (2021). Sooty bark disease of maples: the risk for hypersensitivity pneumonitis by fungal spores not only for woodman. J. Occup. Med. Toxicol.16:2. doi: 10.1186/s12995-021-00292-5
12
Brglez A. Piškur B. Ogris N. (2020). In vitro interactions between Eutypella parasitica and some frequently isolated fungi from the wood of the dead branches of young sycamore maple (Acer pseudoplatanus). Forests11:1072. doi: 10.3390/f11101072
13
Busby P. E. Ridout M. Newcombe G. (2016). Fungal endophytes: modifiers of plant disease. Plant Mol. Biol.90, 645–655. doi: 10.1007/s11103-015-0412-0
14
Bußkamp J. (2018). Schadenserhebung, Kartierung und Charakterisierung des Diplodia-Triebsterbens der Kiefer, insbesondere des endophytischen Vorkommens in den klimasensiblen Räumen und Identifikation von den in Kiefer (Pinus sylvestris) vorkommenden Endophyten. Kassel: Universität Kassel. Available at: https://urn.fi/urn:nbn:de:hebis:34-2018092156417
15
Butt T. M. Copping L. G. (2000). Fungal biological control agents. Outlook11, 186–191. doi: 10.1039/b008009h
16
Cain R. F. (1961). Studies of coprophilus ascomycetes VII. Preussia.Can. J. Bot.39, 1633–1666. doi: 10.1139/b61-144
17
Cazorla F. M. Mercado-Blanco J. (2016). Biological control of tree and woody plant diseases: an impossible task?BioControl61, 233–242. doi: 10.1007/s10526-016-9737-0
18
Chapman B. Xiao G. (2000). Inoculation of stumps withHypholomafasciculareas a possible means to control armillaria root disease. Can. J. Bot.78, 129–134. doi: 10.1139/b99-170
19
Coates D. Rayner A. D. M. (1985). Fungal population and community development in cut beech logs: I. Establishment via the aerial cut surface. New Phytol.101, 153–171. doi: 10.1111/j.1469-8137.1985.tb02823.x
20
Crous P. W. Schumacher R. K. Wingfield M. J. Lombard L. Giraldo A. Christensen M. et al . (2015). Fungal systematics and evolution: FUSE 1. Sydowia67, 81–118. doi: 10.12905/0380.sydowia67-2015-0081
21
De Vrije T. Antoine N. Buitelaar R. M. Bruckner S. Dissevelt M. Durand A. et al . (2001). The fungal biocontrol agent Coniothyrium minitans: production by solid-state fermentation, application and marketing. Appl. Microbiol. Biotechnol.56, 58–68. doi: 10.1007/s002530100678
22
Demir Ö. Zeng H. Schulz B. Schrey H. Steinert M. Stadler M. et al . (2023). Bioactive compounds from an endophytic Pezicula sp. showing antagonistic effects against the ash dieback pathogen. Biomol. Ther.13:1632. doi: 10.3390/biom13111632
23
Desprez-Loustau M.-L. Robin C. Reynaud G. Déqué M. Badeau V. Piou D. et al . (2007). Simulating the effects of a climate-change scenario on the geographical range and activity of forest-pathogenic fungi. Can. J. Plant Pathol.29, 101–120. doi: 10.1080/07060660709507447
24
Dickenson S. J. (1980). Biology of Cryptostroma corticale and the sooty bark disease of sycamore. Ascot: University of Bath.
25
Dickenson S. Wheeler B. E. J. (1981). Effects of temperature, and water stress in sycamore, on growth of Cryptostroma corticale. Trans. Br. Mycol. Soc.76, 181–185. doi: 10.1016/S0007-1536(81)80136-2
26
Domsch K. H. Gams W. Anderson T. H. (1980). Compendium of soil Fungi, vol. 1-2. London: Academic Press.
27
Donnelly D. P. Boddy L. (2001). Mycelial dynamics during interactions between Stropharia caerulea and other cord-forming, saprotrophic basidiomycetes. New Phytol.151, 691–704. doi: 10.1046/j.0028-646x.2001.00211.x
28
Dowson C. G. Rayner A. D. M. Boddy L. (1988). The form and outcome of mycelial interactions involving cord-forming decomposer basidiomycetes in homogeneous and heterogeneous environments. New Phytol.109, 423–432. doi: 10.1111/j.1469-8137.1988.tb03718.x
29
Eastburn D. M. McElrone A. J. Bilgin D. D. (2011). Influence of atmospheric and climatic change on plant–pathogen interactions. Plant Pathol.60, 54–69. doi: 10.1111/j.1365-3059.2010.02402.x
30
Ellis J. B. Everhart B. M. (1889). New species of hyphomycetous fungi. J. Mycol.5, 68–72. doi: 10.2307/3752309
31
Elmholt S. Kjøller A. (1989). Comparison of the occurrence of the saprophytic soil Fungi in two differently cultivated field soils. Biol. Agric. Hortic.6, 229–239. doi: 10.1080/01448765.1989.9754520
32
Enderle R. Riebesehl J. Becker P. Kehr R. (2020). “Rußrindenkrankheit an Ahorn - Biologie, Pathologie und Entsorgung von Schadholz” in Jahrbuch der Baumpflege 2020. ed. DujesiefkenD. (Braunschweig: Haymarket Media), 85–100.
33
Folman L. B. Klein Gunnewiek P. J. A. Boddy L. De Boer W. (2008). Impact of white-rot fungi on numbers and community composition of bacteria colonizing beech wood from forest soil. FEMS Microbiol. Ecol.63, 181–191. doi: 10.1111/j.1574-6941.2007.00425.x
34
Gonzalez-Menendez V. Martin J. Siles J. A. Gonzalez-Tejero M. R. Reyes F. Platas G. et al . (2017). Biodiversity and chemotaxonomy of Preussia isolates from the Iberian Peninsula. Mycol. Progress16, 713–728. doi: 10.1007/s11557-017-1305-1
35
Gregory P. H. Waller S. (1951). Cryptostroma corticale and sooty bark disease of sycamore (Acer pseudoplatanus). Trans. Br. Mycol. Soc.34, 579–IN10. doi: 10.1016/S0007-1536(51)80043-3
36
Greig B. J. W. (1976). Biological control of Fomes annosus by Peniophora gigantea. Forest Pathol.6, 65–71. doi: 10.1111/j.1439-0329.1976.tb00508.x
37
Halecker S. Wennrich J.-P. Rodrigo S. Andrée N. Rabsch L. Baschien C. et al . (2020). Fungal endophytes for biocontrol of ash dieback: the antagonistic potential of Hypoxylon rubiginosum. Fungal Ecol.45:100918. doi: 10.1016/j.funeco.2020.100918
38
Hänsel S. Hoy A. Brendel C. Maugeri M. (2022). Record summers in Europe: variations in drought and heavy precipitation during 1901–2018. Int. J. Climatol.42, 6235–6257. doi: 10.1002/joc.7587
39
Harman G. E. (1991). Seed treatments for biological control of plant disease. Crop Prot.10, 166–171. doi: 10.1016/0261-2194(91)90038-S
40
Harman G. E. Taylor A. G. (1988). Improved seedling performance by integration of biological control agents at favorable pH levels with solid matrix priming. Phytopathology78:520. doi: 10.1094/Phyto-78-520
41
Heiniger U. Rigling D. (1994). Biological control of chestnut blight in Europe. Annu. Rev. Phytopathol.32, 581–599. doi: 10.1146/annurev.py.32.090194.003053
42
Heydari A. Pessarakli M. (2010). A review on biological control of fungal plant pathogens using microbial antagonists. J. Biol. Sci.10, 273–290. doi: 10.3923/jbs.2010.273.290
43
Howell C. R. (2003). Mechanisms employed by Trichoderma species in the biological control of plant diseases: the history and evolution of current concepts. Plant Dis.87, 4–10. doi: 10.1094/PDIS.2003.87.1.4
44
Humber R. A. (1997). “Fungi: Preservation of cultures” in Manual of techniques in insect pathology. ed. LaceyL. A. (Amsterdam: Elsevier), 269–279.
45
Hyde K. de Silva N. Abeywickrama P. Phookamsak R. Jeewon R. Jayawardena R. et al . (2020). AJOM new records and collections of fungi. Asian J. Mycol3, 1–100. doi: 10.5943/ajom/3/1/3
46
Kehr R. D. (1992). Pezicula canker of Quercus rubra L., caused by Pezicula cinnamomea (DC.) sacc.Forest Pathol22, 29–40. doi: 10.1111/j.1439-0329.1992.tb01429.x
47
Kelnarová I. Černý K. Zahradník D. Koukol O. (2017). Widespread infection of Cryptostroma corticale in asymptomatic Acer pseudoplatanus as a risk for urban plantations.For. Pathol.47:e12344. doi: 10.1111/efp.12344
48
Kenis M. Hurley B. P. Colombari F. Lawson S. Sun J. H. Wilcken C. et al . (2019). Guide to the classical biological control of insect pests in planted and natural forests. FAO forestry paper 182. Rome: FAO.
49
Koukol O. Kelnarová I. Černý K. (2014). Recent observations of sooty bark disease of sycamore maple in Prague (Czech Republic) and the phylogenetic placement of Cryptostroma corticale.For. Pathol.45, 21–27. doi: 10.1111/efp.12129
50
Kowalski T. Kehr R. (1992). Endophytic fungal colonization of branch bases in several forest tree species. Sydowia44, 137–168.
51
Langer G. J. (1994). Die Gattung Botryobasidium DONK (Corticiaceae, Basidiomycetes). Berlin: J. Cramer.
52
Langer G. J. Bußkamp J. (2021). Fungi associated with Woody tissues of European beech and their impact on tree health. Front. Virol.12:702467. doi: 10.3389/fmicb.2021.702467
53
Langer G. J. Bußkamp J. Terhonen E. Blumenstein K. (2021). “Fungi inhabiting woody tree tissues” in Forest microbiology. eds. Mataix-SoleraJ.GuerreroC. (New York, NY: Elsevier), 175–205.
54
Lundborg A. Unestam T. (1980). Antagonism against fomes annosus. Comparison between different test methods in vitro and in vivo. Mycopathologia70, 107–115. doi: 10.1007/BF00443076
55
Mapperson R. R. Kotiw M. Davis R. A. Dearnaley J. D. W. (2014). The diversity and antimicrobial activity of Preussia sp. endophytes isolated from Australian dry rainforests. Curr. Microbiol.68, 30–37. doi: 10.1007/s00284-013-0415-5
56
Marx D. H. Daniel W. J. (1976). Maintaining cultures of ectomycorrhizal and plant pathogenic fungi in sterile water cold storage. Can. J. Microbiol.22, 338–341. doi: 10.1139/m76-051
57
Massimo N. C. Nandi Devan M. M. Arendt K. R. Wilch M. H. Riddle J. M. Furr S. H. et al . (2015). Fungal endophytes in aboveground tissues of desert plants: infrequent in culture, but highly diverse and distinctive symbionts. Microb. Ecol.70, 61–76. doi: 10.1007/s00248-014-0563-6
58
McMullin D. R. Green B. D. Prince N. C. Tanney J. B. Miller J. D. (2017). Natural products of Picea endophytes from the Acadian Forest. J. Nat. Prod.80, 1475–1483. doi: 10.1021/acs.jnatprod.6b01157
59
Moreau C. Moreau M. (1951). La‚ Suie’ des Sycamores a Paris. Bullet. Soc. Mycol.67, 404–418.
60
Motlagh M. R. S. Usefipoor P. (2016). Identification of non-pathogenic fungi of rice and the evaluation of their effect on biological control of Pyricularia grisea, the causal agent of rice blast disease in vitro. Hortorum Cultus: Acta Scientiarum Polonorum.
61
Muller E. Dvořák M. Marçais B. Caeiro E. Clot B. Desprez-Loustau M.-L. et al . (2023). Conditions of emergence of the sooty bark disease and aerobiology of Cryptostroma corticale in Europe. NB84, 319–347. doi: 10.3897/neobiota.84.90549
62
Noble H. M. Langley D. Sidebottom P. J. Lane S. J. Fisher P. J. (1991). An echinocandin from an endophytic Cryptosporiopsis sp. and Pezicula sp. in Pinus sylvestris and Fagus sylvatica. Mycol. Res.95, 1439–1440. doi: 10.1016/S0953-7562(09)80401-2
63
Oliva J. Ridley M. Redondo M. A. Caballol M. (2021). Competitive exclusion amongst endophytes determines shoot blight severity on pine. Funct. Ecol.35, 239–254. doi: 10.1111/1365-2435.13692
64
Oliveira Longa C. M. Vai N. Maresi G. (2016). Cryptostroma corticale in the northern Apennines (Italy). Phytopathol. Mediterr.55, 136–138. doi: 10.14601/Phytopathol_Mediterr-17164
65
Perlatti B. Lan N. Xiang M. Earp C. E. Spraker J. E. Harvey C. J. B. et al . (2021). Anti-cryptococcal activity of preussolides a and B, phosphoethanolamine-substituted 24-membered macrolides, and leptosin C from coprophilous isolates of Preussia typharum. J. Ind. Microbiol. Biotechnol.48:22. doi: 10.1093/jimb/kuab022
66
Peters L. P. Prado L. S. Silva F. I. N. Souza F. S. C. Carvalho C. M. (2020). Selection of endophytes as antagonists of Colletotrichum gloeosporioides in açaí palm. Biol. Control150:104350. doi: 10.1016/j.biocontrol.2020.104350
67
Peterson R. A. Bradner J. R. Roberts T. H. Nevalainen K. M. H. (2009). Fungi from koala (Phascolarctos cinereus) faeces exhibit a broad range of enzyme activities against recalcitrant substrates. Lett. Appl. Microbiol.48, 218–225. doi: 10.1111/j.1472-765X.2008.02513.x
68
Plate H. P. Schneider R. (1965). Ein Fall von asthmaartiger Allergie, verursacht durch den Pilz Cryptostroma corticale. Nachrichtenblatt des deutschen Pflanzenschutzdienstes17, 100–101.
69
Porras-Alfaro A. Raghavan S. Garcia M. Sinsabaugh R. L. Natvig D. O. Lowrey T. K. (2014). Endophytic fungal symbionts associated with gypsophilous plants. Botany92, 295–301. doi: 10.1139/cjb-2013-0178
70
Pratt J. E. Gibbs J. N. Webber J. F. (1999). Registration of Phlebiopsis gigantea as a Forest Biocontrol agent in the UK: recent experience. Biocontrol Sci. Tech.9, 113–118. doi: 10.1080/09583159929974
71
Prospero S. Botella L. Santini A. Robin C. (2021). Biological control of emerging forest diseases: how can we move from dreams to reality?For. Ecol. Manag.496:119377. doi: 10.1016/j.foreco.2021.119377
72
R Core Team . (2019). R Core team (2019). European Environment Agency. Available at:https://www.eea.europa.eu/data-and-maps/indicators/oxygen-consuming-substances-in-rivers/r-development-core-team-2006 (Accessed March 18, 2020).
73
Rai J. N. Tewari J. P. (1963). On some isolates of the genus Preussia Fuckel from Indian soils.Proc. Indian Acad. Sci.57, 45–55. doi: 10.1007/BF03053881
74
Rayner A. D. M. Griffith G. S. Wildman H. G. (1994). Induction of metabolic and morphogenetic changes during mycelial interactions among species of higher fungi. Biochem. Soc. Trans.22, 389–394. doi: 10.1042/bst0220389
75
Raziq F. Fox R. T. V. (2003). Comparisons Between the In Vitro and In Vivo Efficacies of Potential Fungal Antagonists of Armillaria mellea.Biol. Agric. Hortic.21, 263–276. doi: 10.1080/01448765.2003.9755269
76
Rigerte L. Blumenstein K. Terhonen E. (2019). New R-based methodology to optimize the identification of root endophytes against Heterobasidion parviporum. Microorganisms7:102. doi: 10.3390/microorganisms7040102
77
Rigling D. Prospero S. (2018). Cryphonectria parasitica, the causal agent of chestnut blight: invasion history, population biology and disease control. Mol. Plant Pathol.19, 7–20. doi: 10.1111/mpp.12542
78
Rishbeth J. (1963). Stump protection against Fomes annosus.Ann. Appl. Biol.52, 63–77. doi: 10.1111/j.1744-7348.1963.tb03728.x
79
Rodriguez R. J. Redman R. S. (1997). Fungal life-styles and ecosystem dynamics: biological aspects of plant pathogens, plant endophytes and saprophytes. Adv. Bot. Res.24, 169–193. doi: 10.1016/S0065-2296(08)60073-7
80
Rossman A. Y. Allen W. C. Castlebury L. Seifert K. Verkley G. (2018). (2609—2613) proposals to conserve Amorphotheca resinae against Cladosporium avellaneum, ditiola mucida (holwaya mucida) against Acrospermum caliciiforme (crinula caliciiformis), lophodermium seditiosum against Leptostroma austriacum, pezicula sporulosa against Gloeosporium longisporum (cryptosporiopsis longispora), and Tapesia yallundae (oculimacula yallundae) against Cercosporella herpotrichioides (pseudocercosporella herpotrichioides) (Ascomycota: leotiomycetes). Taxon67, 636–638. doi: 10.12705/673.18
81
Schlößer R. Bien S. Langer G. J. Langer E. J. (2023). Fungi associated with woody tissues of Acer pseudoplatanus in forest stands with different health status concerning sooty bark disease (Cryptostroma corticale). Mycol Progress22:13. doi: 10.1007/s11557-022-01861-6
82
Schuldt B. Buras A. Arend M. Vitasse Y. Beierkuhnlein C. Damm A. et al . (2020). A first assessment of the impact of the extreme 2018 summer drought on central European forests. Basic Appl. Ecol.45, 86–103. doi: 10.1016/j.baae.2020.04.003
83
Schulz B. Sucker J. Aust H. J. Krohn K. Ludewig K. Jones P. G. et al . (1995). Biologically active secondary metabolites of endophytic Pezicula species. Mycol. Res.99, 1007–1015. doi: 10.1016/S0953-7562(09)80766-1
84
Schumacher J. Leonhard S. Wulf A. Heydeck P. (2006). Bemerkenswerte Vitalitätsschwächung und Holzzersetzung an Rot-Buchen (Fagus sylvatica) durch den weitgehend unbekannten Schlauchpilz Hypoxylon cohaerens. Gesunde Pflanzen58, 225–230. doi: 10.1007/s10343-006-0134-y
85
Shoresh M. Harman G. E. Mastouri F. (2010). Induced systemic resistance and plant responses to fungal Biocontrol agents. Annu. Rev. Phytopathol.48, 21–43. doi: 10.1146/annurev-phyto-073009-114450
86
Sieber T. N. (2007). Endophytic fungi in forest trees: are they mutualists?Fungal Biol. Rev.21, 75–89. doi: 10.1016/j.fbr.2007.05.004
87
Sinclair W. A. Lyon H. H. (2005). Diseases of trees and shrubs. 2nd Edn. Ithaca, NY: Cornell University Press, 169–193.
88
Šnajdr J. Dobiášová P. Větrovský T. Valášková V. Alawi A. Boddy L. et al . (2011). Saprotrophic basidiomycete mycelia and their interspecific interactions affect the spatial distribution of extracellular enzymes in soil. FEMS Microbiol. Ecol.78, 80–90. doi: 10.1111/j.1574-6941.2011.01123.x
89
Song Z.-K. Zhu A.-H. Liu Z.-D. Qu Z. Li Y. Ma H.-X. (2022). Three new species of Hypoxylon (Xylariales, Ascomycota) on a multigene phylogeny from Medog in Southwest China. JoF8:500. doi: 10.3390/jof8050500
90
Sonnenbichler J. Dietrich J. Peipp H. (1994). Secondary fungal metabolites and their biological activities, V. Investigations concerning the induction of the biosynthesis of toxic secondary metabolites in Basidiomycetes. Biol. Chem. Hoppe Seyler375, 71–80. doi: 10.1515/bchm3.1994.375.1.71
91
Stevens R. Reyes G. Kanavillil N. (2020). Examining the impact of winter and spring soil temperatures on the growth of Hypholoma fasciculare, a potential Biocontrol agent against Armillaria ostoyae, in pine plantations. Front. For. Glob. Change3:598527. doi: 10.3389/ffgc.2020.598527
92
Taylor A. G. Harman G. E. (1990). Concepts and Technologies of Selected Seed Treatments. Annu. Rev. Phytopathol.28, 321–339. doi: 10.1146/annurev.py.28.090190.001541
93
Thompson T. A. Thorn R. G. Smith K. T. (2012). Hypholoma lateritium isolated from coarse woody debris, the forest floor, and mineral soil in a deciduous forest in New Hampshire. Botany90, 457–464. doi: 10.1139/b2012-011
94
Thomson B. D. Malajczuk N. Grove T. S. Hardy G. E. (1993). Improving the colonization capacity and effectiveness of ectomycorrhizal fungal cultures by association with a host plant and re-isolation. Mycol. Res.97, 839–844. doi: 10.1016/S0953-7562(09)81159-3
95
Towey J. W. Sweany H. C. Huron W. H. (1932). Severe bronchial asthma apparently due to fungus spores found in maple bark. JAMA99, 453–459. doi: 10.1001/jama.1932.02740580021005
96
Wang Q. Xu L. (2012). Beauvericin, a bioactive compound produced by Fungi: a short review. Molecules17, 2367–2377. doi: 10.3390/molecules17032367
97
Weber H. A. Gloer J. B. (1988). Interference competition among natural fungal competitors: an antifungal metabolite from the coprophilous fungus Preussia fleischhakii. J. Nat. Prod.51, 879–883. doi: 10.1021/np50059a011
98
Weber H. A. Gloer J. B. (1991). The Preussomerins: novel antifungal metabolites from the coprophilous fungus Preussia isomera Cain. J. Org. Chem.56, 4355–4360. doi: 10.1021/jo00014a007
99
Wendt L. Sir E. B. Kuhnert E. Heitkämper S. Lambert C. Hladki A. I. et al . (2018). Resurrection and emendation of the Hypoxylaceae, recognised from a multigene phylogeny of the Xylariales. Mycol Progress17, 115–154. doi: 10.1007/s11557-017-1311-3
100
Whipps J. M. (1987). Effect of media on growth and interactions between a range of soil-borne glasshouse pathogens and antagonistic fungi. New Phytol.107, 127–142. doi: 10.1111/j.1469-8137.1987.tb04887.x
101
Whipps J. M. Gerlagh M. (1992). Biology of Coniothyrium minitans and its potential for use in disease biocontrol. Mycol. Res.96, 897–907. doi: 10.1016/S0953-7562(09)80588-1
102
Woods C. M. Woodward S. Redfern D. B. (2005). In vitro interactions in artificial and wood‐based media between fungi colonizing stumps of Sitka spruce. For. Pathol.35, 213–229. doi: 10.1111/j.1439-0329.2005.00403.x
103
Woodward S. Boddy L. (2008). “Chapter 7 interactions between saprotrophic fungi” in Ecology of saprotrophic Basidiomycetes. eds. BoddyL.FranklandJ. (New York, NY: Elsevier), 125–141.
104
Young C. W. T. (1978). Sooty bark disease of sycamore. London: Stationery Office Books, Department of Environment.
105
Yuan Z.-L. Rao L.-B. Chen Y.-C. Zhang C.-L. Wu Y.-G. (2011). From pattern to process: species and functional diversity in fungal endophytes of Abies beshanzuensis. Fungal Biol.115, 197–213. doi: 10.1016/j.funbio.2010.11.002
106
Yuen T. K. Hyde K. D. Hodgkiss I. J. (1999). Interspecific interactions among tropical and subtropical freshwater Fungi. Microb. Ecol.37, 257–262. doi: 10.1007/s002489900151
Summary
Keywords
fungal endophytes, sooty bark disease, sycamore maple, antagonism, biocontrol
Citation
Schlößer R, Bien S, Bußkamp J, Langer GJ and Langer EJ (2025) On the lookout for a potential antagonist against Cryptostroma corticale—an insight through in vitro dual culture studies. Front. For. Glob. Change 7:1518972. doi: 10.3389/ffgc.2024.1518972
Received
29 October 2024
Accepted
11 December 2024
Published
08 January 2025
Volume
7 - 2024
Edited by
Juan A. Martin, Polytechnic University of Madrid, Spain
Reviewed by
Luisa Ghelardini, University of Florence, Italy
Giorgio Maresi, Fondazione Edmund Mach, Italy
Updates
Copyright
© 2025 Schlößer, Bien, Bußkamp, Langer and Langer.
This is an open-access article distributed under the terms of the Creative Commons Attribution License (CC BY). The use, distribution or reproduction in other forums is permitted, provided the original author(s) and the copyright owner(s) are credited and that the original publication in this journal is cited, in accordance with accepted academic practice. No use, distribution or reproduction is permitted which does not comply with these terms.
*Correspondence: Rebekka Schlößer, rebekka.schloesser@gmx.de
Rebekka Schlößer, https://orcid.org/0000-0003-3827-9505
Steffen Bien, orcid.org/0000-0003-0680-3376
Johanna Bußkamp, orcid.org/0000-0003-0891-175X
Gitta Jutta Langer, orcid.org/0000-0002-9575-0423
Ewald Johannes Langer, orcid.org/0000-0003-3480-2936
Disclaimer
All claims expressed in this article are solely those of the authors and do not necessarily represent those of their affiliated organizations, or those of the publisher, the editors and the reviewers. Any product that may be evaluated in this article or claim that may be made by its manufacturer is not guaranteed or endorsed by the publisher.